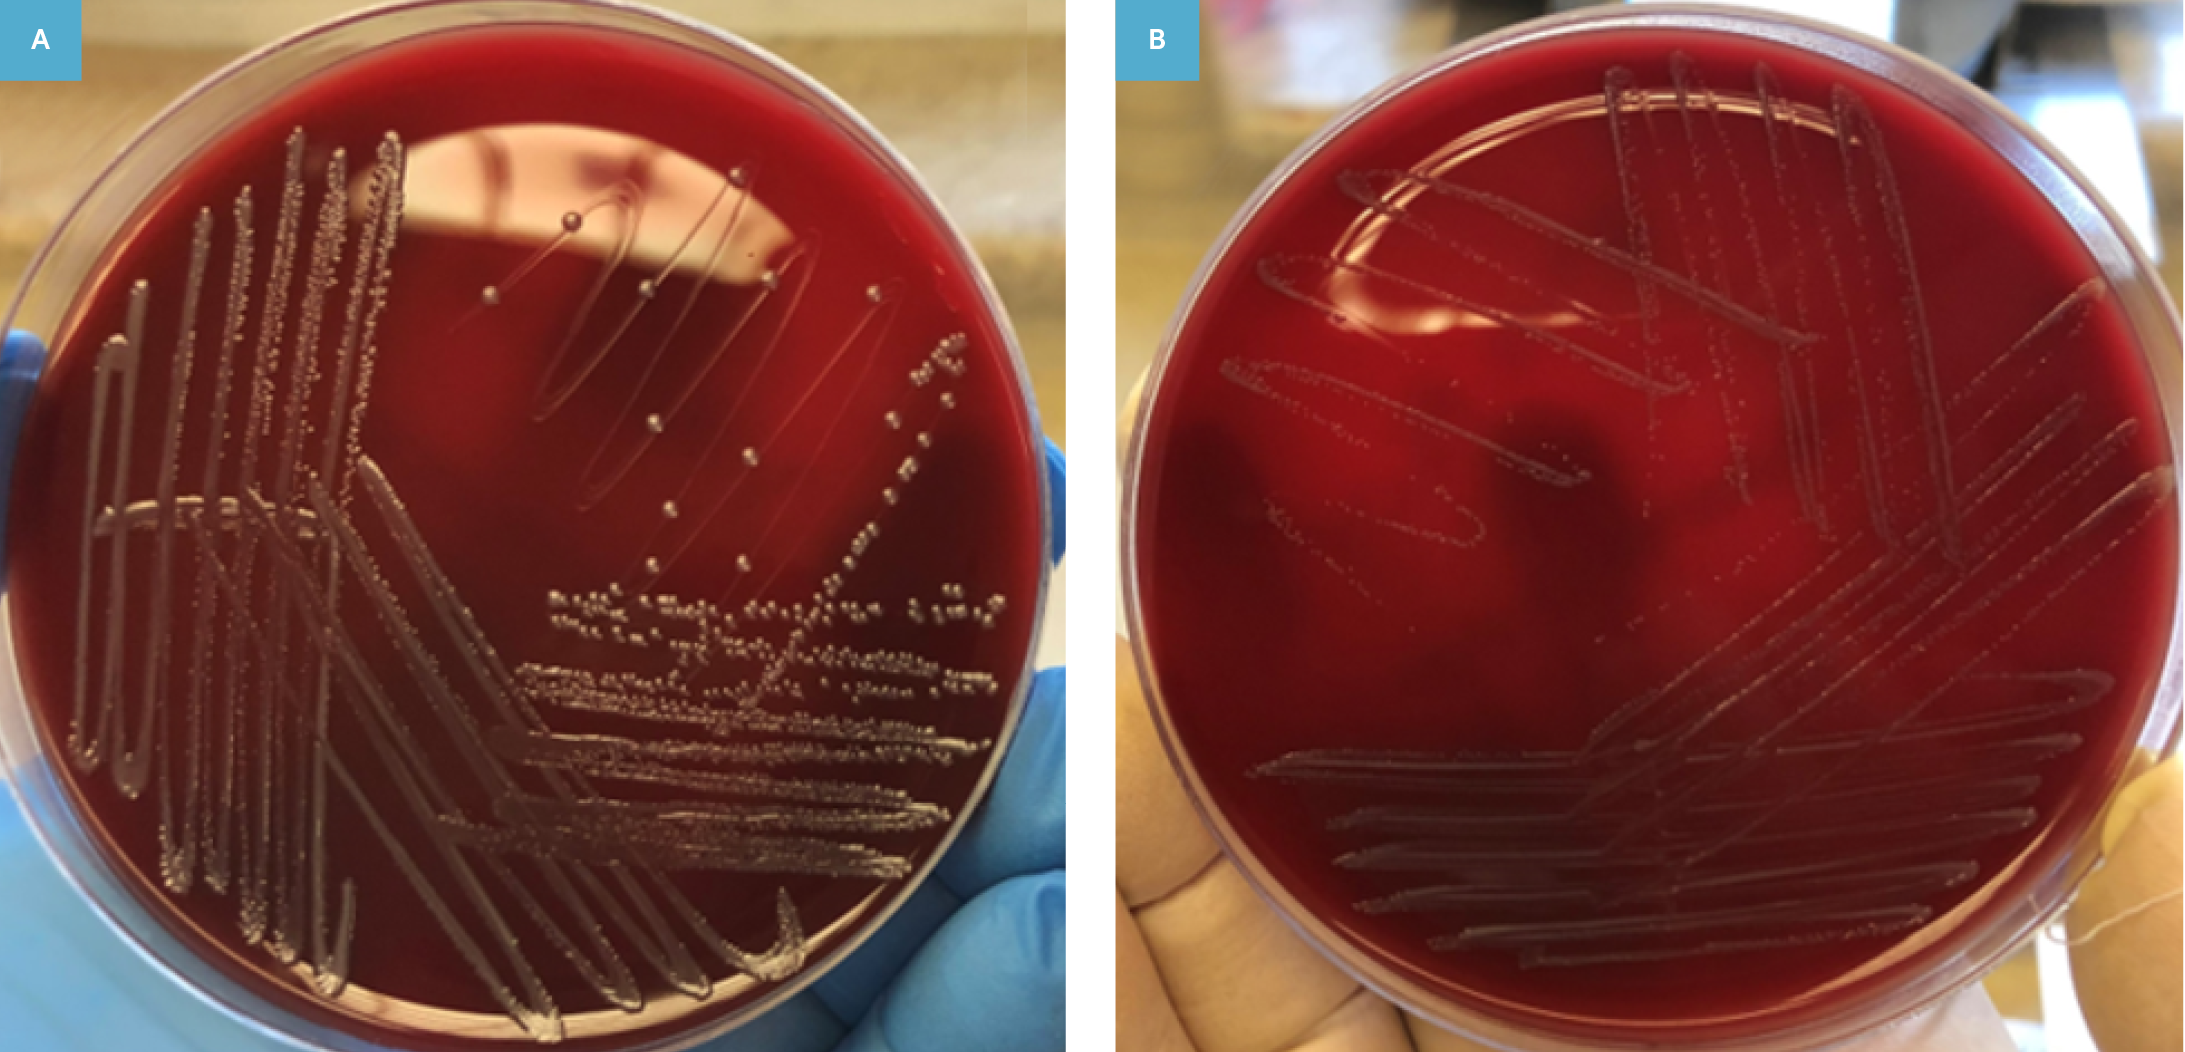

En Çok Okunanlar
Özet
Enterococcus faecalis özellikle hastane kaynaklı kan dolaşımı infeksiyonlarında önemli bir etkendir. Enterokok türlerine bağlı bakteriyemi sıklığının %10 olmasına karşın literatürde genotipik olarak farklı iki E. faecalis suşuna bağlı bir olgu bildirilmemiştir. Bu yazıda sunulan bakteriyemi olgusunda aynı kan kültüründe fenotipik olarak iki farklı E. faecalis suşu üredi ve söz konusu suşların birbirinden genotipik olarak farklı olduğu “pulsed-field” jel elektroforezi (PFGE) ile gösterildi.
GİRİŞ
Enterococcus türleri; Gram-pozitif, kok şeklinde, fakültatif anaerob bakterilerdir. Enterococcus spp. hastane kaynaklı kan dolaşımı infeksiyonlarında en sık izole edilen üçüncü etkendir ve bakteriyemilerin yaklaşık %10’undan sorumludur (1). Enterokoklara bağlı bakteriyemilerde en sık izole edilen tür Enterococcus faecalis olup klinik izolatların %65-70’ini oluşturmaktadır. Enterokok bakteriyemisine bağlı mortalite oranları %19-%50 arasında bildirilmektedir. İleri yaş, komorbidite, hastane kaynaklı bakteriyemi ve uygun olmayan antibiyotik tedavisi mortaliteyi artıran faktörlerdir (2-5). Literatür taraması yapıldığında birbirinden farklı iki E. faecalis suşunun izole edildiği bir bakteriyemi olgusuna rastlanmadı. Aynı kan kültüründen iki E. faecalis izole edilen olgulara bakıldığında ise bunların Enterococcus küçük koloni varyantlarına bağlı infektif endokardit olguları olduğu görüldü. Fakat bu olgularda izole edilen suşların klonal olarak aynı olduğu gösterilmiştir (6-8). Bu yazıda; fenotipik ve genotipik farklılık gösteren iki E. faecalis suşu ile gelişen bir bakteriyemi olgusu sunulmaktadır.
OLGU
Bilinen kronik obstrüktif akciğer hastalığı (KOAH), hipertansiyon, koroner arter hastalığı, konjestif kalp yetmezliği, atrial fibrilasyon, aortik kapak replasmanı ve mitral kapak yetmezliği tanıları olan 81 yaşındaki erkek hasta nefes darlığı, ateş, dizüri şikayetleri ile acil servise başvurdu. Hastanın yapılan fizik muayenesinde; akciğerde raller, karında ve ayaklarda ödemin yanı sıra akciğer tomografisinde kardiyomegali, bilateral plevral efüzyon ve bilateral interstisyel ödem ile uyumlu görünüm saptandı. Hipervolemi ve plevral efüzyon nedeniyle kardiyak değerlendirme için yapılan transtorasik ekokardiyografide (TTE); ejeksiyon fraksiyonu (EF) %45, 3. derece mitral ve triküspid yetmezlik izlendi; vejetasyon saptanmadı. Medikal tedavi planlanan hasta iç hastalıkları servisine yatırıldı. İdrar kültüründe üreyen Escherichia coli için antibiyogramı dikkate alınarak 10 gün seftriakson [2 gram/gün, intravenöz (İV)] verildi. Seftriakson tedavisinden sonra ateş ve dizüri şikayetleri düzeldi. Hastanın şikayeti olmaması nedeniyle kontrol amaçlı idrar kültürü istenmedi. Hastaneye yatışının 15. gününde; kardiyak değerlendirme için yapılan transözofageal ekokardiyografide (TEE); aortik kapak etrafında paravalvüler apse şüphesi uyandıran görünüm ve mitral kapağın ön leafletinde 4×4 mm’lik vejetasyon şüphesi uyandıran alan izlendi. Söz konusu görünümler infektif endokardit açısından şüpheli olduğu için kardiyak bilgisayarlı tomografi (BT) ile değerlendirme önerildi. İnfeksiyon hastalıkları bölümünün önerisi ile 24 saat içinde üç set kan kültürü alındı. Hastadan alınan üç set kan kültürünün birinde iki farklı E. faecalis üremesi oldu. Bundan dört gün sonra hastanın ateşinin yükselmesi üzerine, çıkan ateşi takiben gönderilen bir set kan kültüründe de iki farklı E. faecalis üremesi oldu. Modifiye Duke kriterlerine göre; iki majör (ekokardiyografi bulgusu ve kan kültürü pozitifliği) ve iki minör (ateş ve infektif endokardit için yatkınlık yaratan durum) kriteri karşılaması nedeniyle olgu infektif endokardit olarak değerlendirildi. Yatışının 20. gününde infektif endokardit tanısı ile ampisilin (12 g/gün) ve gentamisin (3 mg/kg/gün) tedavisi başlandı (9). Hastanın ateşi 24 saat içinde düştü ve bir daha tekrarlamadı. Ateşin 24 saatte düşmesi nedeniyle infektif endokardit değerlendirilmesinden uzaklaşıldı ve daha sonra alınan kontrol kan kültürlerinde üreme olmadı. Kardiyak BT’de; aortik valv replasmanı ile ortaya çıkan ve aortaya uygulanan greftin çevresinde aort anevrizması kalıntısı olması muhtemel bir görünüm izlendi; herhangi bir vejetasyon saptanmadı. TEE’de aortik valv etrafındaki apse şüphesi uyandıran görünümün eski anevrizma kalıntısı olabileceği düşünüldü. Yatışının 34. gününde çekilebilen pozitron emisyon tomografisi-bilgisayarlı tomografi (PET-BT) sonucu infektif endokardit yönünden negatif sonuçlandı. Bunun üzerine yatışının 37. ve infektif endokardit için başlanan tedavinin ise 17. gününde antibiyotik tedavisi kesildi.
Mikrobiyoloji laboratuvarına gönderilen kan kültürleri, otomatize BD BACTEC™ FX (Becton Dickinson, ABD) sistemi kullanılarak beş gün inkübe edildi. Hastadan ilk gönderilen üç set kan kültürünün bir setinde 14 saat 56 dakika sonunda ve bundan dört gün sonra çıkan ateşi takiben gönderilen bir set kan kültüründe 21 saat 4 dakikada pozitif sinyal saptandı. Pozitif sinyal veren şişelerden Gram boyama ile yapılan direkt mikroskobik incelemede Gram-pozitif koklar görüldü. Kan kültürü şişelerinden %5 koyun kanlı agara, eozin-metilen mavisi (EMB) agara ve çikolata agara ekim yapıldı. Koyun kanlı agar ve çikolata agar CO2’li etüvde, EMB agar ise aerobik etüvde 37 °C’de inkübe edildi. Yirmi dört saatlik inkübasyonun ardından; %5 koyun kanlı agarda gri, düz, nonhemolitik ve biri büyük (Suş A) diğeri ise küçük (Suş B) olan iki farklı fenotipte koloni üremesi gözlendi (Resim 1). Çikolata agarda da benzer şekilde üreme olurken, EMB agarda üreme saptanmadı. Üreyen farklı fenotipteki mikroorganizmaların her ikisi de konvansiyonel testler ve matriks aracılı lazer desorpsiyon/iyonizasyon-uçuş zamanlı kütle spektrometresi [(MALDI-TOF-MS) (Bruker Daltonik GmbH, Almanya)] sistemi ile >2 skorla E. faecalis olarak tanımlandı.
E. faecalis suşlarının antibiyotik duyarlılık testleri BD Phoenix™ (Becton Dickinson, ABD) otomatize sistemi ile gerçekleştirildi. Antibiyotik duyarlılık test sonuçları Avrupa Antimikrobiyal Duyarlılık Testleri Komitesi (“European Committee on Antimicrobial Susceptibility Testing – EUCAST”) rehberine göre değerlendirildi ve her iki suş da test edilen tüm antibiyotiklere duyarlı bulundu (Tablo 1) (10). Fenotipik olarak farklılık gösteren iki E. faecalis suşunun klonal ilişkisi “pulsed field” jel elektroforezi (PFGE) yöntemi ile araştırıldı. PFGE yönteminde jelde oluşan değişik sayı ve boyutlardaki DNA bantları yazılım analiz sistemine aktarıldı ve izolatlar arası ilişkilendirme sayısal olarak yapıldı. GelCompar II ver. 3.0 (Applied Maths, Belçika) yazılım sistemi kullanılarak bant profilleri analiz edildi. İstatistiksel analiz kapsamında; UPGMA (“Unweighted Pair Group Method with Mathematical Averaging”) kullanımı yoluyla PFGE profillerinin dendrogramı oluşturuldu ve kümeleşme analizi yapıldı. “Dice” benzerlik katsayısına göre bantlara bağlı olarak suşlar arasındaki ilişki belirlendi (Resim 2). Tenover kriterlerindeki bant farklılıkları göz önüne alınarak, dendogramda %90-95 arası benzerlik grubuna giren pulsotipler birbiriyle ayırt edilemez olarak kabul edildi; %90-85 aralığındakiler yakın ilişkili, %85’in altında benzerlik gösterenler ise farklı pulsotip olarak değerlendirildi. Suşların arasında %69 oranında benzerlik bulunduğu ve iki suşun birbirinden genotipik olarak farklı olduğu tespit edildi (11, 12).
İRDELEME
Enterokoklara bağlı kan dolaşımı infeksiyonları sıklıkla üriner sistem ya da intraabdominal bir odakla ilişkilidir. Endovasküler kateterler, infektif endokardit ve solunum sistemi diğer görülen odaklar olmakla birlikte olguların yaklaşık üçte birinde odak bilinmemektedir (3, 13). Olgumuzda başlangıçta bakteriyemi odağı infektif endokardit olarak düşünüldü. Fakat kardiyak BT, PET-BT ve ikinci kez yapılan TEE sonuçları değerlendirildiğinde infektif endokardit tanısı dışlandı. Yapılan tetkiklerde bakteriyemiye neden olan bir odak bulunamadı.
Son yıllarda antibiyotik direnç oranlarının artması, virulans faktörlerinin kazanılması ve biyofilm oluşturma kapasitesi nedeniyle hastane ilişkili infeksiyonlarda Enterococcus spp. sık rastlanan bakterilerdir. Enterococcus spp. klinikte kullanılan çoğu antibiyotiğe direnç geliştirme potansiyeline sahiptir. Tüm enterokoklar, sefalosporinlere intrinsik olarak dirençlidir. Ampisilin, aminoglikozidler ve glikopeptidlere karşı kazanılmış direncin prevalansı artmaktadır. Yapılan çalışmalarda, antibiyotik direnci ve mortalite E. faecalis izolatlarında E. faecium’a göre daha düşük bulunmuştur (3, 13). Bu olguda izole edilen iki farklı E. faecalis suşu test edilen tüm antibiyotiklere duyarlı bulundu.
Kan kültürü, kan dolaşımı infeksiyonlarının tanısında altın standarttır. Kan kültürlerinin uygun endikasyonlarla, uygun yöntemle ve uygun miktarda alınarak laboratuvara gönderilmesi doğru tanı koymada büyük öneme sahiptir. Alınan kan miktarının gerektiğinden az ya da fazla olması, örnek alımının ardından laboratuvara teslim süresinin iki saati aşması veya bakteriyeminin aralıklı olması yanlış negatif sonuçlara neden olabilir (14). Olgumuzda başlangıçta alınan üç set kan kültürünün yalnızca bir setinde üreme olup diğerlerinde olmaması bu faktörlere bağlı olabilir. Enterococcus spp.’nin tek kan kültüründe üremesi durumunda %11-30 oranında kontaminasyon kaynaklı olabileceği bildirilmiştir (15). Ancak, olgumuzda daha sonra alınan bir set kan kültüründe de aynı bakterinin üremesi kontaminasyon olasılığını dışlamıştır.
Literatürde, küçük koloni varyantları dışında kan kültüründe iki farklı E. faecalis izole edilen olgu bulunmamaktadır. Küçük koloni varyantları; normal koloni morfolojisine göre daha küçük, yavaş üreyen, fenotipik ve metabolik özellikleri farklılık gösteren bakterilerdir. Antibiyotik direnç oranlarının normal fenotipe göre yüksek olması tedavide zorluğa neden olmaktadır (8). Kan kültürlerinden E. faecalis’in küçük koloni varyantlarının etken olarak izole edildiği nadir infektif endokardit olguları bulunmaktadır. Fakat bu raporlarda bizim olgumuzdan farklı olarak izole edilen suşların klonal olarak aynı olduğu PFGE ile gösterilmiştir (6-8).
Sonuç olarak; kültür plaklarında farklı fenotipte görülen bakteriler identifikasyon testlerinin ardından aynı mikroorganizma olarak tanımlansa da ayrı ayrı değerlendirilmeli ve antibiyotik duyarlılık testleri her izolat için yapılmalıdır. Kan kültüründen fenotipik olarak iki farklı E. faecalis izole edilmesi durumunda bu suşların küçük koloni varyantı ya da iki farklı suş olabileceği göz önünde bulundurulmalıdır.
Hasta Onamı
Hastadan bilgilendirilmiş onam formu alınmıştır.
Danışman Değerlendirmesi
Bağımsız dış danışman.
Yazar Katkıları
Fikir/Kavram – M.D.Ç., A.C.G., G.H., Ö.U.; Tasarım – G.H., Ö.U.; Denetleme – G.H., Ö.U.; Kaynak ve Fon Sağlama – G.H., Ö.U.; Malzemeler/Hastalar – A.C.G., Ö.U.; Veri Toplama ve/veya İşleme – M.D.Ç., A.C.G.; Analiz ve/veya Yorum – M.D.Ç., A.C.G., G.H., Ö.U.; Literatür Taraması – M.D.Ç., A.C.G.; Makale Yazımı – M.D.Ç., A.C.G.; Eleştirel İnceleme – G.H., Ö.U.
Çıkar Çatışması
Yazarlar herhangi bir çıkar çatışması bildirmemiştir.
Finansal Destek
Yazarlar finansal destek beyan etmemiştir.
Referanslar
- Liesman RM, Pritt BS, Maleszewski JJ, Patel R. Laboratory diagnosis of infective endocarditis. J Clin Microbiol. 2017;55(9):2599-608. [CrossRef]
- Suppli M, Aabenhus R, Harboe ZB, Andersen LP, Tvede M, Jensen JU. Mortality in enterococcal bloodstream infections increases with inappropriate antimicrobial therapy. Clin Microbiol Infect. 2011;17(7):1078-83. [CrossRef]
- Pinholt M, Ostergaard C, Arpi M, et al. Incidence, clinical characteristics and 30-day mortality of enterococcal bacteraemia in Denmark 2006-2009: a population-based cohort study. Clin Microbiol Infect. 2014;20(2):145-51. [CrossRef]
- Pericás JM, Zboromyrska Y, Cervera C, et al. Enterococcal endocarditis revisited. Future Microbiol. 2015;10(7):1215-40. [CrossRef]
- Alkan S, Kuloğlu F, Akata F. [Evaluation of risk factors in enterococcal bloodstream infections]. Klimik Derg. 2016;29(2):65-70. Turkish. [CrossRef]
- Ogihara S, Saito R, Sawabe E, Hagihara M, Tohda S. First Japanese case of infectious endocarditis due to Enterococcus faecalis small-colony variants. J Infect Chemother. 2016;22(10):716-9. [CrossRef]
- Benes J, Dzupova O, Setina M, Feuereisl R, Svec P, Pantucek R. Relapsing endocarditis caused by Enterococcus faecalis forming small colony variants. Scand J Infect Dis. 2013;45(10):800-3. [CrossRef]
- Wellinghausen N, Chatterjee I, Berger A, Niederfuehr A, Proctor RA, Kahl BC. Characterization of clinical Enterococcus faecalis small-colony variants. J Clin Microbiol. 2009;47(9):2802-11. [CrossRef]
- Li JS, Sexton DJ, Mick N, et al. Proposed modifications to the Duke Criteria for the diagnosis of infective endocarditis. Clin Infect Dis. 2000;30(4):633-8. [CrossRef]
- Breakpoint tables for interpretation of MICs and zone diameters. Version 10.0. [İnternet]. Växjö: European Committee on Antimicrobial Susceptibility Testing (EUCAST). [Ocak 2020; erişim 2 Aralık 2020]. https://www.eucast.org/ast_of_bacteria/previous_versions_of_documents/
- Werner G, Coque TM, Franz CM, Grohmann E, Hegstad K, Jensen L, et al. Antibiotic resistant enterococci-tales of a drug resistance gene trafficker. Int J Med Microbiol. 2013;303(6-7):360-79. [CrossRef]
- Sánchez-Sanhueza G, Villegas C, Ulloa, et al. Molecular typing of Enterococcus faecalis from persistent endodontic infections. Int J Odontostomat. 2018;12(1):113-9.
- Billington EO, Phang SH, Gregson DB, et al. Incidence, risk factors, and outcomes for Enterococcus spp. blood stream infections: a population-based study. Int J Infect Dis. 2014;26:76-82. [CrossRef]
- Tıbbi Mikrobiyoloji Uzmanları İçin Klinik Örnekten Sonuç Raporuna Uygulama Rehberi: Kan Dolaşımı Örnekleri Rehberi [İnternet]. Ankara: Klinik Mikrobiyoloji Uzmanlığı Derneği (KLİMUD). [Eylül 2017; erişim 2 Aralık 2020]. https://www.klimud.org/public/uploads/content/files/Kan%20Dola%C5%9F%C4%B1m%C4%B1%20%C3%B6rnekleri.pdf
- Khatib R, Labalo V, Sharma M, Johnson LB, Riederer K. Enterococcus spp. in a single blood culture: bacteremia or contamination? Diagn Microbiol Infect Dis. 2017;87(3):289-90. [CrossRef]